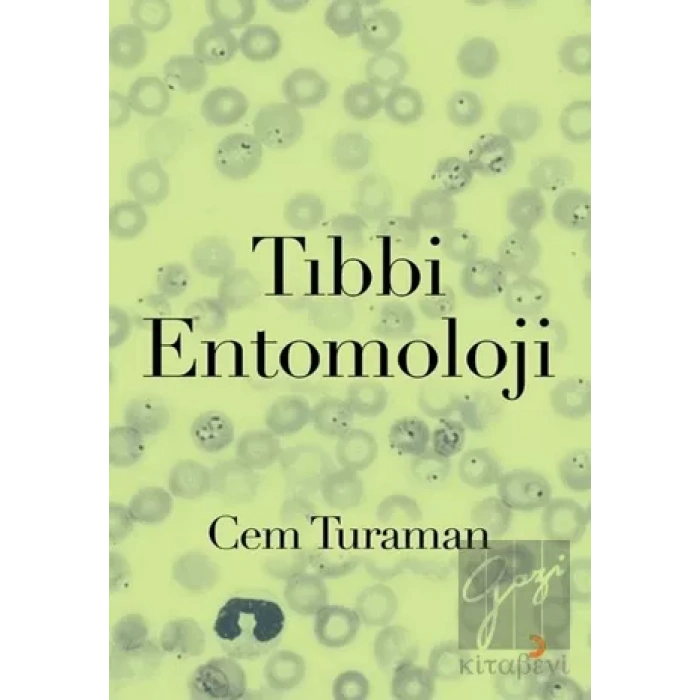
Tıbbi Entomoloji

Tıbbi entomoloji disiplini halen eksikli olarak biyolojinin tekelindedir ve tıp bu konudan bihaberdir, bu kitapla bir çifte eksiği tamamlıyorum. Kitap kendi alanında, Türkçede tektir, yabancı dillerde de, hem böceği hem de hastalıkları derinlemesine ele alan tek tıbbi entomoloji kitabı olmakla, benzersizdir ve bu konuda az sayıda kitap bulunmaktadır. Konu sıralamasında hastalık değil böcek sistematiği sırasına uydum, kitabın adındaki ağırlık noktası, "entomoloji"dir.
Yolun henüz başında olmamıza karşılık, kitabın kapsamını olabildiği kadar geniş tutmayı, tıp ile entomolojinin kesişme alanında bulunması gereken her konuya yer vermeyi hedefledim. Konuları standart bir format halinde sundum. Önce işi yapan böcek, sonra ortaya çıkan sonuç ve bu sonucun çözümü. Böcek-insan karşılaşmasından ortaya çıkan sağlık sorunları hakkında ise halk sağlığı prensibiyle, epidemiyolojik ölçülerle başlayıp, bir tıp öğrencisini doyuracak kadar belirti ve bulgular, teşhis ve tedavi seçenekleri, korunma ve kontrol sırasını izledim.
Yine de bu alanda yazılabileceklerin belki henüz hepsini yazmamışımdır, okuyucu katkısı bu yüzden de bir zorunluluktur ve bekliyorum.
Biyoloji ve tıptan başka, veterinerlik, kimya ve farmakoloji gibi farklı alanların ilgisine açık bir disiplin olarak, tıbbi entomolojinin hepsinin ilgisini çekmesini umuyorum, böyle farklı disiplinleri ilgilendiren bu yeni alanın ülkemizde gelişmesi ve eğitim müfredatına girmesi gerekmektedir, umarım kitap bu amaca hizmet eder.